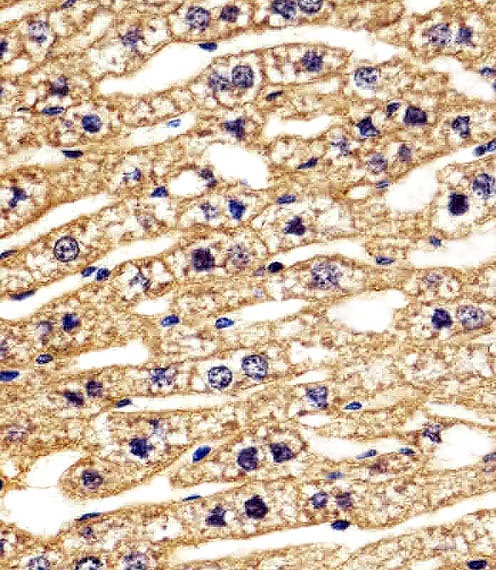

You have no items in your shopping cart.
STRADA Antibody
Catalog Number: orb1265008
| Catalog Number | orb1265008 |
|---|---|
| Category | Antibodies |
| Description | STRADA Antibody |
| Species/Host | Rabbit |
| Clonality | Polyclonal |
| Tested applications | FC, IF, IHC-P, WB |
| Predicted Reactivity | Monkey |
| Reactivity | Human, Mouse |
| Isotype | Rabbit Ig |
| Immunogen | This STRADA antibody is generated from a rabbit immunized with a KLH conjugated synthetic peptide between 303-346 amino acids from the C-terminal region of human STRADA. |
| Antibody Type | Primary Antibody |
| Concentration | batch dependent |
| Form/Appearance | Liquid |
| Conjugation | Unconjugated |
| MW | 48 kDa |
| Target | STRADA |
| UniProt ID | Q7RTN6 |
| NCBI | Q7RTN6 |
| Storage | Maintain refrigerated at 2-8°C for up to 2 weeks. For long term storage store at -20°C in small aliquots to prevent freeze-thaw cycles. |
| Buffer/Preservatives | Supplied in PBS with 0.09% (W/V) sodium azide. |
| Alternative names | STE20-related kinase adapter protein alpha, STRAD Read more... |
| Note | For research use only |
| Application notes | For IHC-P starting dilution is: 1:25For IF starting dilution is: 1:25For FACS starting dilution is: 1:25For WB starting dilution is: 1:1000 |
| Expiration Date | 12 months from date of receipt. |

Immunohistochemical analysis of paraffin-embedded H. duodenum section using STRADA Antibody. Antibody was diluted at 1:100 dilution. A peroxidase-conjugated goat anti-rabbit IgG at 1:400 dilution was used as the secondary antibody, followed by DAB staining.

Fluorescent image of A549 cells stained with STRADA Antibody. AP20607C was diluted at 1:25 dilution. An Alexa Fluor 488-conjugated goat anti-rabbit lgG at 1:400 dilution was used as the secondary antibody (green). Cytoplasmic actin was counterstained with Alexa Fluor 555 conjugated with Phalloidin (red).

Flow cytometric analysis of SH-SY5Y cells using STRADA Antibody (green) compared to an isotype control of rabbit IgG (blue). Antibody was diluted at 1:25 dilution. An Alexa Fluor 488 goat anti-rabbit lgG at 1:400 dilution was used as the secondary antibody.

Immunohistochemical analysis of paraffin-embedded H. liver section using STRADA Antibody. Antibody was diluted at 1:100 dilution. A peroxidase-conjugated goat anti-rabbit IgG at 1:400 dilution was used as the secondary antibody, followed by DAB staining.

Immunohistochemical analysis of paraffin-embedded M. duodenum section using STRADA Antibody. Antibody was diluted at 1:100 dilution. A peroxidase-conjugated goat anti-rabbit IgG at 1:400 dilution was used as the secondary antibody, followed by DAB staining.
Immunohistochemical analysis of paraffin-embedded M. liver section using STRADA Antibody. Antibody was diluted at 1:100 dilution. A peroxidase-conjugated goat anti-rabbit IgG at 1:400 dilution was used as the secondary antibody, followed by DAB staining.

Western blot analysis of lysates from 293T cell line human brain and mouse brain tissue lysate (from left to right), using STRADA Antibody at 1:1000 at each lane.
STRADA Antibody (C-term) [orb1788123]
FC, IF, IHC-P, WB
Human, Mouse
Rabbit
Polyclonal
Unconjugated
100 μlSTRADA Antibody (C-term) [orb1927155]
FC, IF, IHC-P, WB
Human, Mouse
Rabbit
Polyclonal
Unconjugated
50 μl, 100 μlAnti-STRAD alpha Antibody [orb411732]
FC, IF, WB
Human
Rabbit
Polyclonal
Unconjugated
50 μl, 100 μl, 200 μl
























